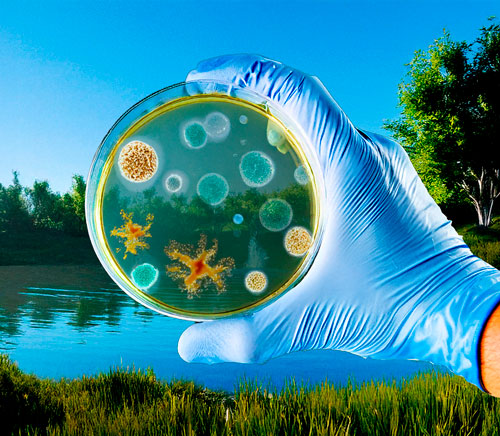

-

Nossas Soluções
Nossas Soluções
Soluções Biotecnológicas Sustentáveis para um Mundo Mais Limpo
Na Biota Indústria de Biotecnologia, desenvolvemos produtos inovadores com tecnologia sustentável e biodegradável, garantindo eficiência e mínimo impacto ambiental. Todos os nossos produtos são projetados para reduzir resíduos, otimizar processos industriais e regenerar ambientes, seguindo os mais altos padrões de qualidade.
N7 Plus - Fertilizer of the future
Fertilizantes revestidos com produtos necessários a diversas culturas agronômicas, encapsulado à base orgânica (nitrogenado ou potássio), para liberação controlada, podendo ser formulado agregando nutrientes (micros e macros) e aceleradores de crescimento.
Fertil Fire - The Best Ecologic Fire Control
É um produto organo-mineral, desenvolvido para a utilização no combate a incêndios de qualquer origem. Possui ação extintora, tamponante e refrigerante, características úteis no combate direto ao fogo e, ainda, para a criação de barreiras ou linhas de defesa preventivas capazes de evitar o avanço de incêndios, principalmente os florestais.
Ecotrat TR-II
É um produto de primeira linha destinado ao tratamento químico de água (Torres de Resfriamento, Águas Paradas, Caldeiras e Equipamentos à Vapor). Possui uma perfeita combinação de reagentes em um só produto mono-componente.
DC-M - Purificação do Diesel
A tecnologia DC-M representa uma revolução no mercado de hidrocarbonetos líquidos, em especial o diesel combustível comum, pois oferece uma solução capaz de atender as expectativas de redução das suas emissões a um custo competitivo, proporcionando ainda benefícios energéticos, logísticos e econômicos.
Ecosolid - Solo
Produto de formulação equilibrada para aplicação em solos diversos com objetivo de reduzir a poeira levantada dos equipamentos automotivos em estradas não pavimentadas e cobertura de montes artificiais dentro das mineradoras, selando a superfície sem prejudicar a composição dos materiais ou alterando o seu PH.
nAtive - Biorremediação Avançada
O nAtive é um processo biotecnológico exclusivo e patenteado pelo Grupo Nortnova, baseado na bioaumentação de microbiota nativa. Utilizamos microrganismos altamente especializados para acelerar a degradação de poluentes em águas, solos e efluentes industriais, promovendo a recuperação natural dos ecossistemas.

Spia – Lubrificante Biodegradável
O Spia é um lubrificante biodegradável e ecológico, desenvolvido para oferecer máxima performance na redução de atrito e desgaste de componentes mecânicos, sem comprometer o meio ambiente. Sua fórmula inovadora garante proteção prolongada, resistência térmica e compatibilidade com diferentes tipos de equipamentos industriais.
100%
biodegradável
Reduz emissões e
impacto ambiental
Alta durabilidade e
resistência térmica
Novos Produtos em Desenvolvimento
Além do Spia, estamos constantemente inovando e desenvolvendo novas soluções biotecnológicas. Em breve, apresentaremos mais produtos com a mesma qualidade, tecnologia e compromisso sustentável que fazem parte do nosso DNA.
Fique atento às novidades!
Quer saber mais? Entre em contato conosco e descubra como nossos produtos podem transformar seu negócio.
Usamos cookies para proporcionar melhor desempenho e experiência de navegação. Ao continuar navegando neste site, você declara estar ciente dessas condições. Política de Privacidade Termos de Uso